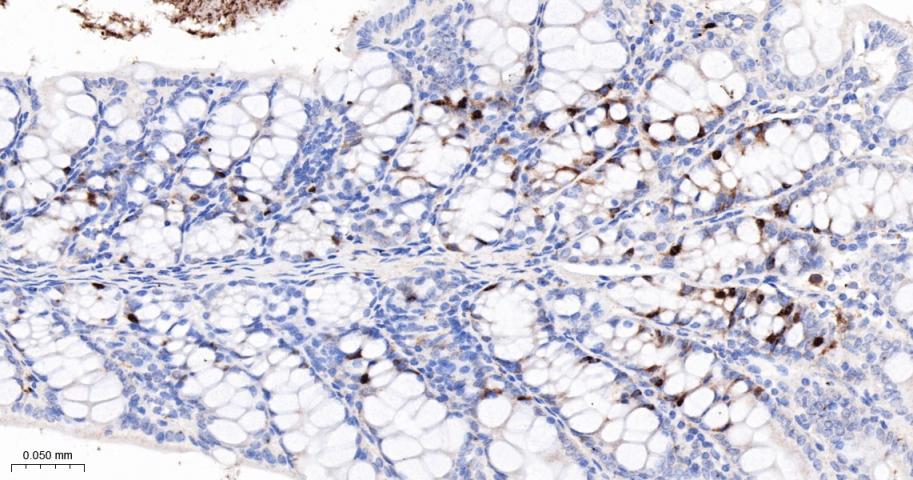
CCNA2 Recombinant Rabbit mAb(b
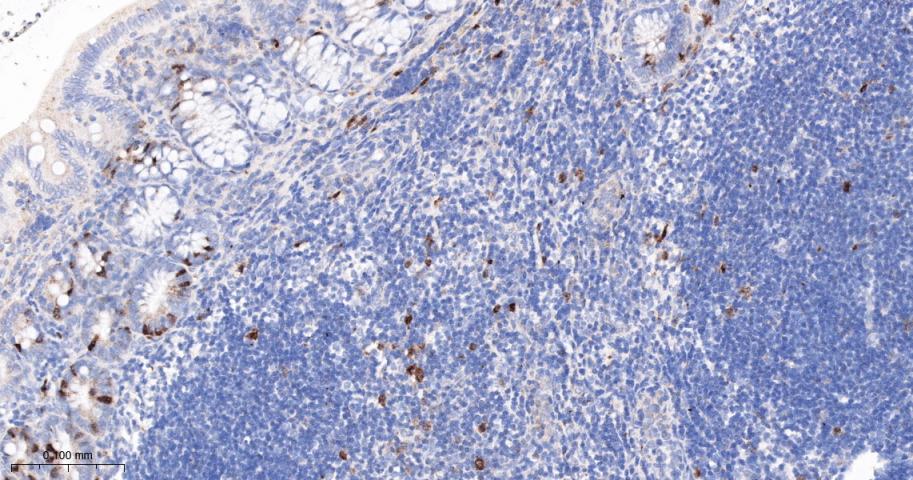
CCNA2 Recombinant Rabbit mAb(b

| 产品编号 | bsm-52660R |
| 英文名称 | CCNA2 Recombinant Rabbit mAb |
| 中文名称 | 周期素A2重组兔单抗 |
| 英文别名 | CCNA2_HUMAN; Cyclin-A2; Cyclin-A; CCN1; CCN1; CCNA; cyclin A2; |
| 产品应用 | WB=1:500-2000, IHC-P=1:50-200, IHC-F=1:50-200, ICC/IF=1:50-200, IF=1:50-200
Not yet tested in other applications.
Optimal working dilutions must be determined by the end user. |
| 交叉反应 | Human, Mouse, Rat |
| 抗体来源 | Rabbit |
| 免疫原 | A synthesized peptide derived from human Cyclin A2 |
| 亚型 | IgG |
| 性状 | Liquid |
| 纯化方法 | affinity purified by Protein A |
| 克隆类型 | Recombinant |
| 理论分子量 | 49 kDa |
| 浓度 | 1mg/ml |
| 储存液 | 1*TBS (pH7.4), 0.05% BSA, 40% Glycerol. Preservative: 0.02% Proclin300. |
| 研究领域 | Cancer > Cell cycle > Cyclins > Cyclin A family Cardiovascular > Lipids / Lipoproteins > Lipoproteins/Apolipoproteins > Apolipoproteins Cell Biology > Cell Cycle > Cyclins Cell Biology > Cell Cycle > Cyclins > Cyclin A Family Epigenetics and Nuclear Signaling > Cell cycle > Cyclins > Cyclin A Family |
| 亚基 | Interacts with the CDK1 and CDK2 protein kinases to form a serine/threonine kinase holoenzyme complex. The cyclin subunit imparts substrate specificity to the complex. When associated with CDK2 (but not with CDK1), interacts with SCAPER. |
| 亚细胞定位 | Nucleus. Cytoplasm. Note=Cytoplasmic when associated with SCAPER. |
| 翻译后修饰 | Polyubiquitinated via 'Lys-11'-linked ubiquitin by the anaphase-promoting complex (APC/C), leading to its degradation by the proteasome. Deubiquitinated and stabilized by USP37 enables entry into S phase. |
| 相似性 | Belongs to the cyclin family. Cyclin AB subfamily. |
| 功能 | Essential for the control of the cell cycle at the G1/S (start) and the G2/M (mitosis) transitions. |
| 保存条件 | Shipped at 4℃. Store at -20℃ for one year. Avoid repeated freeze/thaw cycles. |
| 注意事项 | This product as supplied is intended for research use only, not for use in human, therapeutic or diagnostic applications. |
| 背景资料 | The protein encoded by this gene belongs to the highly conserved cyclin family, whose members function as regulators of the cell cycle. This protein binds and activates cyclin-dependent kinase 2 and thus promotes transition through G1/S and G2/M. [provided by RefSeq, Aug 2016] |
| 应用 | 推荐稀释比例 |
| {WB} | {1:500-2000} |
| {IHC-P} | {1:50-200} |
| {IHC-F} | {1:50-200} |
| {ICC/IF} | {1:50-200} |
| {IF} | {1:50-200} |
Paraformaldehyde-fixed, paraffin embedded Mouse Testicles; Antigen retrieval by boiling in sodium citrate buffer (pH6.0) for 15 min; The section was incubated with CCNA2 Monoclonal Antibody, Unconjugated (bsm-52660R) at 1:200 overnight at 4°C, followed by conjugation to the bs-0295G-HRP and DAB (C-0010) staining.
Paraformaldehyde-fixed, paraffin embedded Rat Testicles; Antigen retrieval by boiling in sodium citrate buffer (pH6.0) for 15 min; The section was incubated with CCNA2 Monoclonal Antibody, Unconjugated (bsm-52660R) at 1:200 overnight at 4°C, followed by conjugation to the bs-0295G-HRP and DAB (C-0010) staining.
Paraformaldehyde-fixed, paraffin embedded Human Testicles; Antigen retrieval by boiling in sodium citrate buffer (pH6.0) for 15 min; The section was incubated with CCNA2 Monoclonal Antibody, Unconjugated (bsm-52660R) at 1:200 overnight at 4°C, followed by conjugation to the bs-0295G-HRP and DAB (C-0010) staining.
Paraformaldehyde-fixed, paraffin embedded Mouse Colon; Antigen retrieval by boiling in sodium citrate buffer (pH6.0) for 15 min; The section was incubated with CCNA2 Monoclonal Antibody, Unconjugated (bsm-52660R) at 1:200 overnight at 4°C, followed by conjugation to the bs-0295G-HRP and DAB (C-0010) staining.
Paraformaldehyde-fixed, paraffin embedded Rat Colon; Antigen retrieval by boiling in sodium citrate buffer (pH6.0) for 15 min; The section was incubated with CCNA2 Monoclonal Antibody, Unconjugated (bsm-52660R) at 1:200 overnight at 4°C, followed by conjugation to the bs-0295G-HRP and DAB (C-0010) staining.
Paraformaldehyde-fixed, paraffin embedded Human Colon; Antigen retrieval by boiling in sodium citrate buffer (pH6.0) for 15 min; The section was incubated with CCNA2 Monoclonal Antibody, Unconjugated (bsm-52660R) at 1:200 overnight at 4°C, followed by conjugation to the bs-0295G-HRP and DAB (C-0010) staining.
Paraformaldehyde-fixed, paraffin embedded Mouse Thymus; Antigen retrieval by boiling in sodium citrate buffer (pH6.0) for 15 min; The section was incubated with CCNA2 Monoclonal Antibody, Unconjugated (bsm-52660R) at 1:200 overnight at 4°C, followed by conjugation to the bs-0295G-HRP and DAB (C-0010) staining.
Paraformaldehyde-fixed, paraffin embedded Rat Thymus; Antigen retrieval by boiling in sodium citrate buffer (pH6.0) for 15 min; The section was incubated with CCNA2 Monoclonal Antibody, Unconjugated (bsm-52660R) at 1:200 overnight at 4°C, followed by conjugation to the bs-0295G-HRP and DAB (C-0010) staining.
Paraformaldehyde-fixed, paraffin embedded Human Lung Cancer; Antigen retrieval by boiling in sodium citrate buffer (pH6.0) for 15 min; The section was incubated with CCNA2 Monoclonal Antibody, Unconjugated (bsm-52660R) at 1:200 overnight at 4°C, followed by conjugation to the bs-0295G-HRP and DAB (C-0010) staining.
Paraformaldehyde-fixed, paraffin embedded Human Colon Cancer; Antigen retrieval by boiling in sodium citrate buffer (pH6.0) for 15 min; The section was incubated with CCNA2 Monoclonal Antibody, Unconjugated (bsm-52660R) at 1:200 overnight at 4°C, followed by conjugation to the bs-0295G-HRP and DAB (C-0010) staining.
Paraformaldehyde-fixed, paraffin embedded Human Cervical Cancer; Antigen retrieval by boiling in sodium citrate buffer (pH6.0) for 15 min; The section was incubated with CCNA2 Monoclonal Antibody, Unconjugated (bsm-52660R) at 1:200 overnight at 4°C, followed by conjugation to the bs-0295G-HRP and DAB (C-0010) staining.
Paraformaldehyde-fixed, paraffin embedded Human Gastric Cancer; Antigen retrieval by boiling in sodium citrate buffer (pH6.0) for 15 min; The section was incubated with CCNA2 Monoclonal Antibody, Unconjugated (bsm-52660R) at 1:200 overnight at 4°C, followed by conjugation to the bs-0295G-HRP and DAB (C-0010) staining.
Paraformaldehyde-fixed, paraffin embedded Human Tonsil; Antigen retrieval by boiling in sodium citrate buffer (pH6.0) for 15 min; The section was incubated with CCNA2 Monoclonal Antibody, Unconjugated (bsm-52660R) at 1:200 overnight at 4°C, followed by conjugation to the bs-0295G-HRP and DAB (C-0010) staining.
Paraformaldehyde-fixed, paraffin embedded Human Endometrial Cancer; Antigen retrieval by boiling in sodium citrate buffer (pH6.0) for 15 min; The section was incubated with CCNA2 Monoclonal Antibody, Unconjugated (bsm-52660R) at 1:200 overnight at 4°C, followed by conjugation to the bs-0295G-HRP and DAB (C-0010) staining.
25 ug total protein per lane of various lysates (see on figure) probed with CCNA2 monoclonal antibody, unconjugated (bsm-52660R) at 1:1000 dilution and 4°C overnight incubation. Followed by conjugated secondary antibody incubation at r.t. for 60 min.

文献和实验
文献和实验 技术资料
技术资料




